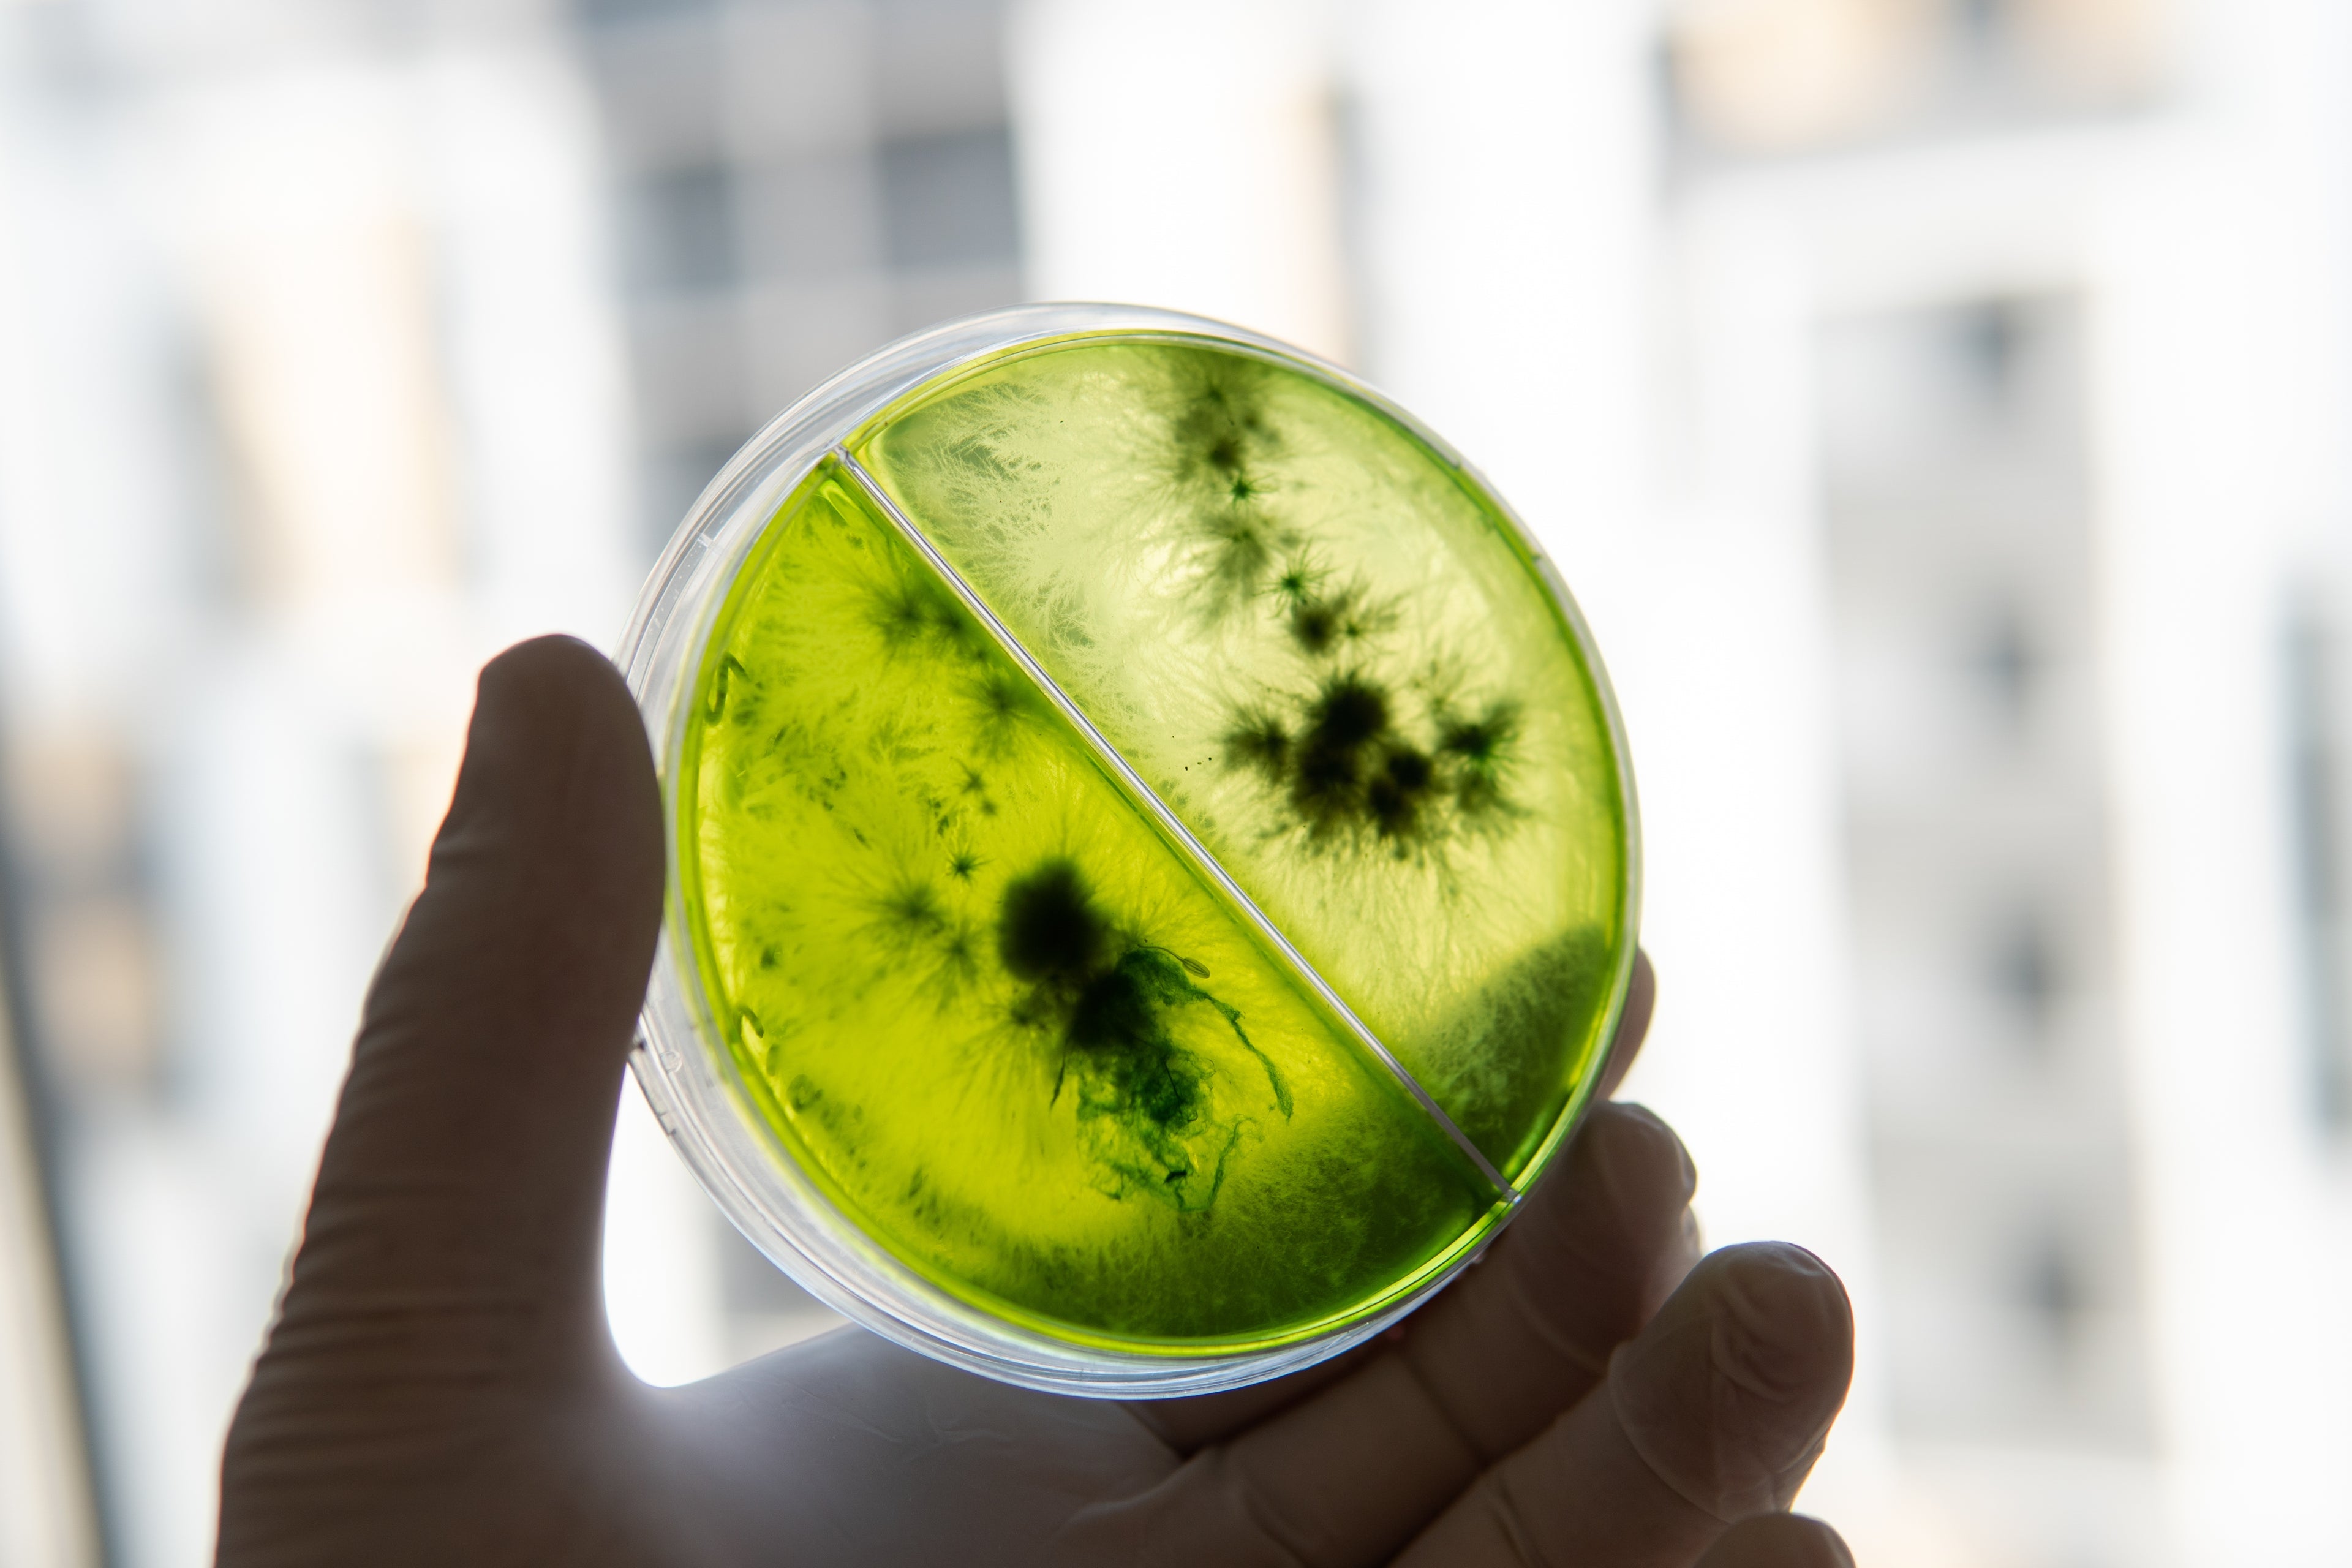

Producción de micelio colonizado de alta calidad
Atención
Personalizada
Métodos de Pagos
Seguros
Envíos a Todo Chile
100% Calidad de
Productos


Nuestros Productos
Innovación y
sostenibilidad en cada
cultivo
Transformamos la gastronomía y cuidamos el
medio ambiente
2000
Clientes felices
8
Años en laburo
60
Productos en venta
10000
Productos vendidos